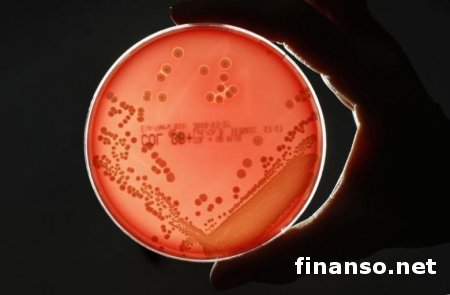
Учеными создан суперантибиотик, убивающий опасные бактерии

Учеными создан суперантибиотик, убивающий опасные бактерииКатегория: Технологии
Американские ученые-медики сумели таким образом модифицировать структуру антибиотика ванкомицина, что он стал уничтожать микробы, вырабатывавшие ранее устойчивость к первой, оригинальной версии указанного медпрепарата, сообщило издание PNAS. Американские ученые-медики сумели таким образом модифицировать структуру антибиотика ванкомицина, что он стал уничтожать микробы, вырабатывавшие ранее устойчивость к первой, оригинальной версии указанного медпрепарата, сообщило издание PNAS. По информации корреспондентов «Украина сегодня: Finanso.net», эту версию ванкомицина медики могут использовать без каких-либо опасений, что микробами может выработаться устойчивость к его молекулам. По заявлению одного из авторов этой модификации лекарства Д. Боуджера из американского Института Скриппса в Ла-Хойе, на бактерии препарат действует тремя различными путями, вследствие чего многократно возрастает его «живучесть». Сообщается, что одновременно искать пути решения трех разных задач микробы просто не в состоянии, так как даже если они преодолели один механизм действия, то два других их непременно убьют. По информации исследователей, среди возбудителей инфекций есть как редкие микробы, так и опасные и очень распространенные патогены, среди которых пневмококк (Klebsiella pneumoniae) и золотистый стафилококк (Staphilococcus aureus). «Инкубаторы» микробов – больницы и животноводческие фермы.По мнению ученых, сегодня основными «инкубаторами» таких опасных микробов являются животноводческие фермы и больницы. На фермах антибиотики применяются в качестве ускорения роста мясных пород скота. Большое количество как потенциальных носителей такой инфекции, самих бактерий и антибиотиков сосредоточено как на фермах, так и в больницах, заставляя их эволюционировать и не позволяя «обычным» бактериям вытеснить менее плодовитые супермикробы. Потенциальное решение этой проблемы было найдено Д. Боуджером с коллегами, сумевшим модифицировать ванкомицин, используемый в медпрактике почти шестьдесят лет, к которому из-за этого некоторые из микробов стали вырабатывать устойчивость. Новая версия ванкомицина может стать эффективной в течение пятидесяти лет, прежде чем стойкость к ней начнут вырабатывать микробы. Сообщается, что главной проблемой указанной «версии» антибиотика является сложность его производства, которое включает 30 различных стадий довольно сложных реакций. Однако это, по мнению автора модификации Д. Боуджера, уже не является проблемой, поскольку сегодня число реакций уже можно сократить до 26 или даже до 18 шагов, а в будущем и до меньшего числа. |
Уважаемый посетитель, Вы зашли на сайт как незарегистрированный пользователь. Мы рекомендуем Вам зарегистрироваться либо зайти на сайт под своим именем.



